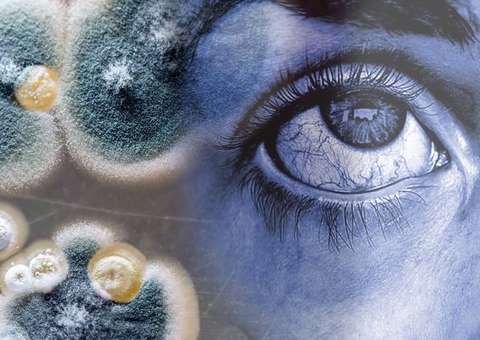
Morre paciente com suspeita de ‘fungo preto’ no Mato Grosso do Sul

A Polícia Civil do Rio de Janeiro montou uma força-tarefa para apurar as circunstâncias do desabamento do prédio na comunidade de Rio das Pedras, na zona oeste do Rio, na madrugada de hoje (3), e o possível envolvimento de milicianos em construções irregulares na região.
A força-tarefa é integrada pela 16ª DP (Barra da Tijuca), a 32ª DP (Taquara), a Delegacia de Proteção ao Meio Ambiente e a Delegacia de Repressão às Ações Criminosas Organizadas e Inquéritos Especiais.
Segundo informações preliminares da polícia, o imóvel que desabou foi construído há mais de 20 anos por pessoas que moravam no local e a construção não teria ligação com a milícia.
Policiais civis estiveram na comunidade e conversaram com testemunhas e vítimas.
A perícia no local começará a ser feita assim que os bombeiros liberarem a área.
“Diligências já estão sendo realizadas para esclarecer as causas do desabamento e o possível envolvimento de milicianos em outros empreendimentos imobiliários da região”, completou, em nota.

Aviso